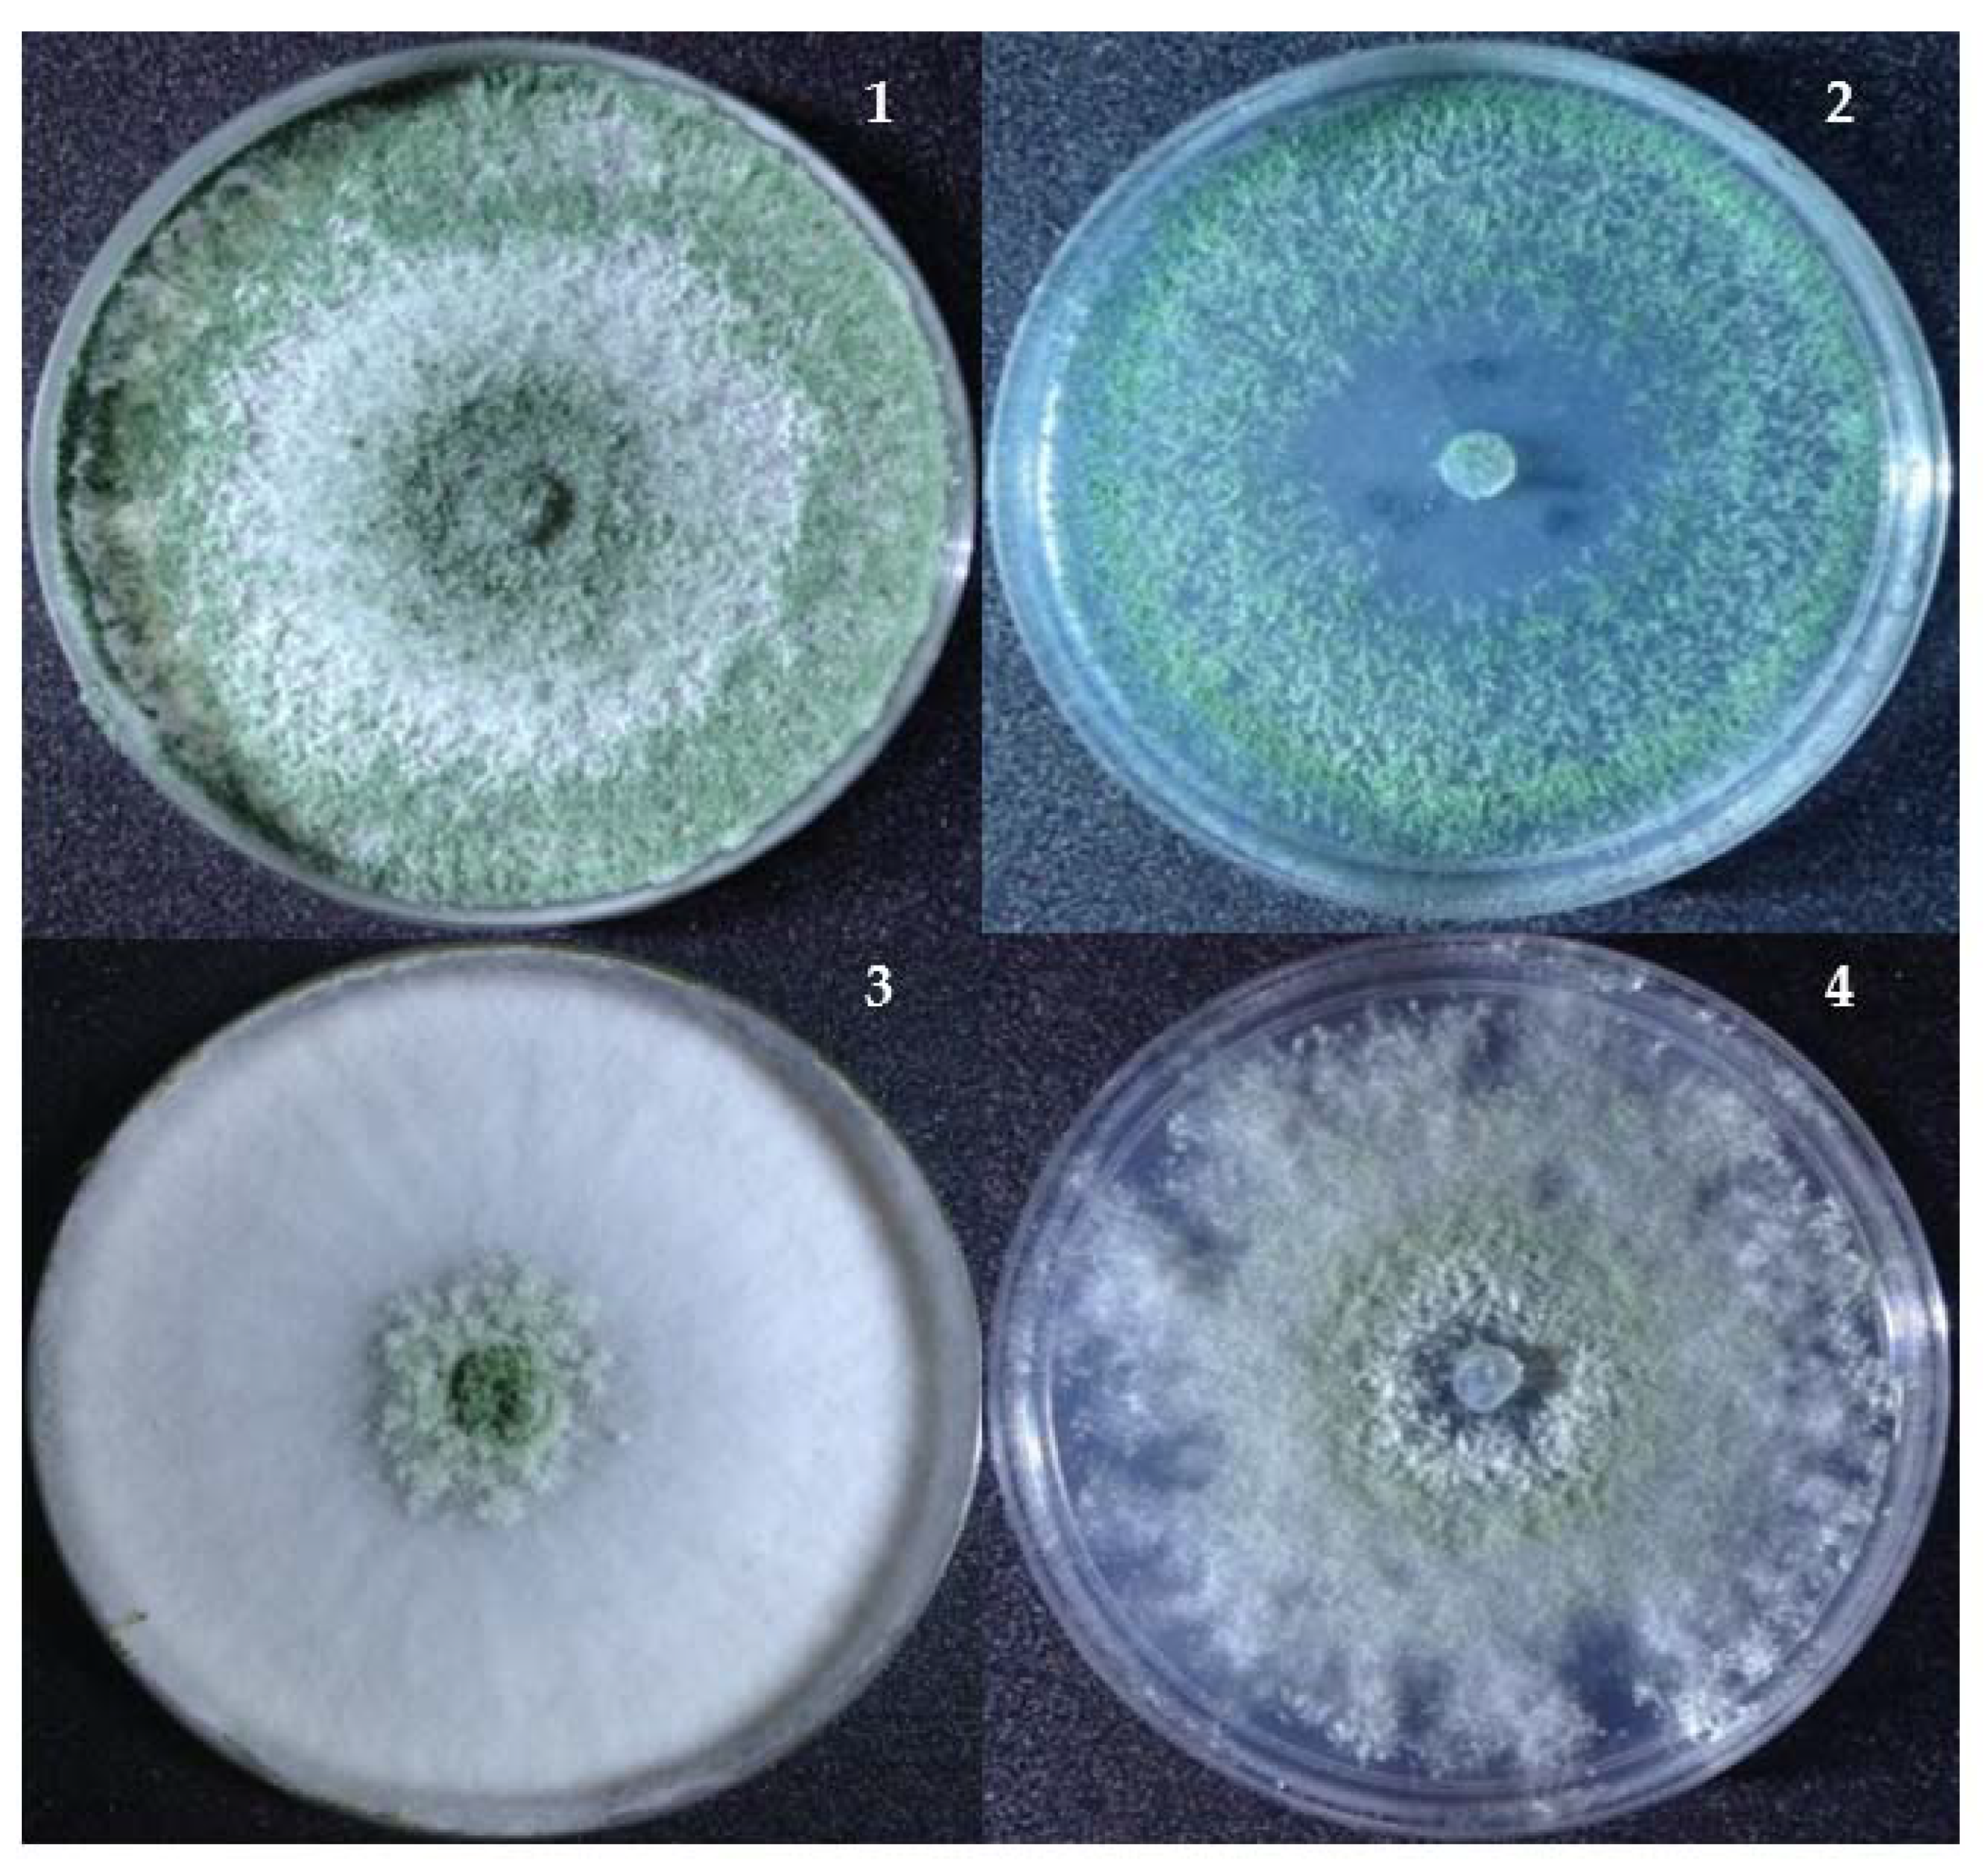
Jof 07 00591 g004 Jof 07 00591 g004

Isolation and Characterization of Nickel-Tolerant Trichoderma Strains from Marine and Terrestrial Environments
Abstract
1. Introduction
2. Materials and Methods
2.1. Substrates Collection
2.2. Isolation of Trichoderma
2.2.1. Soil
2.2.2. Leaf Litter, Seaweeds, and Seagrasses
2.2.3. Seawater and Sea Foam
2.3. Polyphasic Approach to the Characterization of Isolated Trichoderma
2.4. Adaptation of Trichoderma Strains to Marine Environment
2.5. Assay for Heavy Metal Tolerance of Trichoderma Strains
2.6. Biosorption Assay of Nickel by Trichoderma
2.7. Evaluation of Surface Morphology of Trichoderma Grown on PDB with Nickel
3. Results
3.1. The Isolated Trichoderma Strains
3.2. Adaptation of the Isolated Trichoderma to the Marine Environment
3.3. Tolerance of Nickel by Marine and Terrestrial Trichoderma
3.4. Effect of Nickel Exposure on the Surface Morphology of Trichoderma
3.5. Biosorption Capacity of Isolated Trichoderma Strains
4. Discussion
5. Conclusions
Author Contributions
Funding
Institutional Review Board Statement
Informed Consent Statement
Acknowledgments
Conflicts of Interest
References
- Guerra, F.; Trevizam, A.; Muraoka, T.; Marcante, N.; Brazaca, S. Heavy Metals in Vegetables and Potential Risk for Human Health. Sci. Agric. 2011, 69, 54–60. [Google Scholar] [CrossRef]
- Selvi, A.; Rajasekar, A.; Theerthagiri, J.; Ananthaselvam, A.; Sathishkumar, K.; Madhavan, J.; Rahman, P.K.S.M. Integrated Remediation Processes Toward Heavy Metal Removal/Recovery from Various Environments—A Review. Front. Environ. Sci. 2019, 7, 66. [Google Scholar] [CrossRef]
- Hazrat, L.; Ezzat, K.; Ikram, I. Environmental Chemistry and Ecotoxicology of Hazardous Heavy Metals: Environmental Persistence, Toxicity, and Bioaccumulation. J. Chem. 2019, 2019, 6730305. [Google Scholar]
- Genchi, G.; Carocci, A.; Lauria, G.; Sinicropi, M.S.; Catalano, A. Nickel: Human Health and Environmental Toxicology. Int. J. Environ. Res. Public Health 2020, 17, 679. [Google Scholar] [CrossRef]
- Liaquat, F.; Munis, M.; Haroon, U.; Arif, S.; Saqib, S.; Zaman, W.; Khan, A.; Shi, J.; Che, S.; Liu, Q. Evaluation of Metal Tolerance of Fungal Strains Isolated from Contaminated Mining Soil of Nanjing, China. Biology 2020, 9, 469. [Google Scholar] [CrossRef]
- Shivakumar, C.K.; Thippeswamy, B.; Krishnappa, M. Optimization of Heavy Metals Bioaccumulation in Aspergillus niger and Aspergillus flavus. Int J. Environ. Biol. 2014, 4, 188–195. [Google Scholar]
- Thippeswamy, B.; Shivakumar, C.K.; Krishnappa, M. Bioaccumulation Potential of Aspergillus niger and Aspergillus flavus for Removal of Heavy Metals from Paper Mill Effluent. J. Environ. Biol. 2012, 33, 1063–1068. [Google Scholar]
- Mendoza, R.A.J.; Estanislao, K.; Aninipot, J.F.; Dahonog, R.A.; de Guzman, J.; Torres, J.M.O.; dela Cruz, T.E.E. Biosorption of Mercury by the Marine Fungus Dendryphiella salina. Acta Manil. 2010, 58, 25–29. [Google Scholar]
- Carascal, M.B.; del Rosario, M.J.G.; Notarte, K.I.R.; Huyop, F.; Yaguchi, T.; dela Cruz, T.E.E. Butachlor Biodegradation Potential of Fungi Isolated from Submerged Wood and Surface Water Collected in Taal Lake, Philippines. Philipp. Sci. Lett. 2017, 10, 81–88. [Google Scholar]
- Rea-Maminta, M.A.D.; Dagamac, N.H.A.; Huyop, F.Z.; Wahab, R.A.; dela Cruz, T.E.E. Comparative Diversity and Heavy Metal Miosorption of Myxomycetes (Slime Molds) From Forest Patches on Ultramafic and Volcanic Soils. Chem. Ecol. 2015, 31, 741–753. [Google Scholar] [CrossRef]
- Tripathi, P.; Singh, P.C.; Mishra, A.; Chauhan, P.S.; Dwivedi, S.; Bais, R.T.; Tripathi, R.D. Trichoderma: A Potential Bioremediator for Environmental Clean Up. Clean Techn. Environ. Policy 2013, 15, 541–550. [Google Scholar] [CrossRef]
- Sehrawat, A.; Phour, M.; Kumar, R.; Sindhu, S.S. Bioremediation of Pesticides: An Eco-Friendly Approach for Environment Sustainability. In Microbial Rejuvenation of Polluted Environment: Microorganisms for Sustainability; Panpatte, D.G., Jhala, Y.K., Eds.; Springer: Singapore, 2021; Volume 25. [Google Scholar] [CrossRef]
- Alothman, Z.; Bahkali, A.; Elgorban, A.; Al-Otaibi, M.; Ghfar, A.; Gabr, S.; Wabaidur, S.; Habila, M.; Ahmed, A. Bioremediation of Explosive TNT by Trichoderma viride. Molecules 2020, 25, 1393. [Google Scholar] [CrossRef] [PubMed]
- Daccò, C.; Nicola, L.; Temporiti, M.E.E.; Mannucci, B.; Corana, F.; Carpani, G.; Tosi, S. Trichoderma: Evaluation of Its Degrading Abilities for the Bioremediation of Hydrocarbon Complex Mixtures. Appl. Sci. 2020, 10, 3152. [Google Scholar] [CrossRef]
- Zafra, G.; Cortés-Espinosa, D.V. Biodegradation of Polycyclic Aromatic Hydrocarbons by Trichoderma Species: A Mini Review. Environ. Sci. Pollut. Res. 2015, 22, 19426–19433. [Google Scholar] [CrossRef] [PubMed]
- Farah, A.; Amaria, M.; Omar, R.; Mohamed, B.; Zitouni, B. Tolerance of Trichoderma sp. to Heavy Metals and its Antifungal Activity in Algerian Marine Environment. J. Pure Appl. Microbiol. 2018, 12, 855–870. [Google Scholar]
- Nongmaithem, N.; Roy, A.; Bhattacharya, P.M. Screening of Trichoderma Isolates for Their Potential of Biosorption of Nickel and Cadmium. Braz. J. Microbiol. 2016, 47, 305–313. [Google Scholar] [CrossRef]
- Lopez, E.; Vazquez, C. Tolerance and Uptake of Heavy Metals by Trichoderma atroviridae Isolated from Sludge. Chemosphere 2003, 50, 137–143. [Google Scholar] [CrossRef]
- Maya, R.; Robert, R.; Robert, F.; Carly, M. Soil Fungal Communities Differ between Shaded and Sun-Intensive Coffee Plantations in El Salvador. PLoS ONE 2020, 15. [Google Scholar] [CrossRef]
- Kim, K.; Heo, Y.M.; Jang, S.; Lee, H.; Kwon, S.-L.; Park, M.S.; Lim, Y.W.; Kim, J.J. Diversity of Trichoderma spp. in Marine Environments and Their Biological Potential for Sustainable Industrial Applications. Sustainability 2020, 12, 4327. [Google Scholar] [CrossRef]
- Cocaign, A.; Bui, L.C.; Silar, P.; Chan Ho Tong, L.; Busi, F.; Lamouri, A.; Mougin, C.; Rodrigues-Lima, F.; Dupret, J.M.; Dairou, J. Biotransformation of Trichoderma spp. and their Tolerance to Aromatic Amines, a Major Class of Pollutants. Appl. Environ. Microbiol. 2013, 79, 4719–4726. [Google Scholar] [CrossRef]
- Williams, J.; Clarkson, J.; Mills, P.; Cooper, R. A Selective Medium for Quantitative Reisolation of Trichoderma harzianum from Agaricus bisporus Compost. Appl. Environ. Microbiol. 2003, 69, 4190–4191. [Google Scholar] [CrossRef] [PubMed][Green Version]
- Bissett, J. A Revision of the Genus Trichoderma. II. Infrageneric Classification. Can. J. Bot. 2011, 69, 2357–2372. [Google Scholar] [CrossRef]
- Zhu, H.; Qu, F.; Zhu, L.H. Isolation of Genomic DNAs from Plants, Fungi and Bacteria Using Benzyl Chloride. Nucleic Acids Res. 1993, 21, 5279–5280. [Google Scholar] [CrossRef] [PubMed]
- White, T.J.; Bruns, T.; Lee, S.; Taylor, J. Amplification and Direct Sequencing of Fungal Ribosomal RNA Genes for Phylogenetics. In PCR Protocols: A Guide to Methods and Applications; Innis, M.A., Gelfand, D.H., Sninsky, J.J., White, T.J., Eds.; Academic Press: San Diego, CA, USA, 1990; pp. 315–322. [Google Scholar]
- Toju, H.; Tanabe, A.S.; Yamamoto, S.; Sato, H. High-coverage ITS Primers for the DNA-based Identification of Ascomycetes and Basidiomycetes in Environmental Samples. PLoS ONE 2012, 7, e40863. [Google Scholar] [CrossRef]
- Hall, T.A. Bioedit: A User-Friendly Biological Sequence Alignment Editor and Analysis Program for Window 95/98/NT. Nucleic Acids Symp. Ser. 1999, 41, 95–98. [Google Scholar]
- Kumar, S.; Stecher, G.; Tamura, K. MEGA7: Molecular Evolutionary Genetics Analysis version 7.0 for Bigger Datasets. Mol. Biol. Evol. 2016, 33, 1870–1874. [Google Scholar] [CrossRef]
- dela Cruz, T.E.; Wagner, S.; Schulz, B. Physiological Responses of Marine Dendryphiella Species from Different Geographical Locations. Mycol. Prog. 2006, 5, 108–119. [Google Scholar] [CrossRef]
- Smily, J.R.M.B.; Sumithra, P.A. Optimization of Chromium Biosorption by Fungal Adsorbent, Trichoderma sp. BSCR02 and its Desorption Studies. Hayati J. Biosci. 2017, 24, 65–71. [Google Scholar] [CrossRef]
- Lieckfeldt, E.; Samuels, G.J.; Nirenberg, H.I.; Petrini, O. A Morphological and Molecular Perspective of Trichoderma viride: Is it One or Two Species? Appl. Environ. Microbiol. 1999, 65, 2418–2428. [Google Scholar] [CrossRef]
- Ma, J.; Tsegaye, E.; Li, M.; Wu, B.; Jiang, X. Biodiversity of Trichoderma from Grassland and Forest Ecosystems in Northern Xinjiang, China. 3 Biotech 2020, 10, 362. [Google Scholar] [CrossRef]
- Braithwaite, M.; Johnston, P.R.; Ball, S.L.; Nourozi, F.; Hay, A.J.; Shoukouhi, P.; Chomic, A.; Lange, C.; Ohkura, M.; Nieto-Jocobo, M.F.; et al. Trichoderma Down under: Species Diversity and Occurrence of Trichoderma in New Zealand. Australas. Plant Pathol. 2017, 46, 11–30. [Google Scholar] [CrossRef]
- Gal-Hemed, I.; Atanasova, L.; Komon-Zelazowska, M.; Druzhinina, I.S.; Viterbo, A.; Yarden, O. Marine Isolates of Trichoderma spp. as Potential Halotolerant Agents of Biological Control for Arid-Zone Agriculture. Appl. Environ. Microbiol. 2011, 77, 5100–5109. [Google Scholar] [CrossRef]
- Solis, M.J.; Draeger, S.; dela Cruz, T.E.E. Marine-derived Fungi from Kappaphycus alvarezii and K. striatum as Potential Causative Agents of Ice-Ice Disease in Farmed Seaweeds. Bot. Mar. 2010, 53, 587–594. [Google Scholar] [CrossRef]
- Lavadia, M.G.B.; Dagamac, N.H.A.; dela Cruz, T.E.E. Diversity and Biofilm Inhibition Activities of Algicolous Fungi Collected from Two Remote Islands of the Philippine Archipelago. Curr. Res. Environ. Appl. Mycol. 2017, 7, 309–321. [Google Scholar] [CrossRef]
- Notarte, K.I.; Yaguchi, T.; Suganuma, K.; dela Cruz, T.E. Antibacterial, Cytotoxic and Trypanocidal Activities of Marine-Derived Fungi Isolated from Philippine Macroalgae and Seagrasses. Acta Bot. Croat. 2018, 77, 141–151. [Google Scholar] [CrossRef]
- Notarte, K.I.; Nakao, Y.; Yaguchi, T.; Bungihan, M.; Suganuma, K.; dela Cruz, T.E. Trypanocidal Activity, Cytotoxicity and Histone Modifications Induced by Malformin A1 Isolated from the Marine-Derived Fungus Aspergillus tubingensis IFM 63452. Mycosphere 2017, 8, 111–120. [Google Scholar] [CrossRef]
- Wang, C.; Zhuang, W.Y. Carbon Metabolic Profiling of Trichoderma Strains Provides Insight into Potential Ecological Niches. Mycologia 2020, 112, 213–223. [Google Scholar] [CrossRef] [PubMed]
- Fuentes, M.E.; Quiñones, R.A. Carbon Utilization Profile of The Filamentous Fungal Species Fusarium fujikuroi, Penicillium decumbens, and Sarocladium strictum Isolated from Marine Coastal Environments. Mycologia 2016, 108, 1069–1081. [Google Scholar]
- Dela Cruz, T.E.E.; Schulz, B.E.; Kubicek, C.P.; Druzhinina, I.S. Carbon Source Utilization by Marine Dendryphiella Species D. arenaria and D. salina. FEMS Microbiol Ecol. 2006, 58, 343–353. [Google Scholar] [CrossRef]
- Gorai, P.S.; Barman, S.; Gond, S.K.; Mandal, N.C. Trichoderma. In Beneficial Microbes in Agro-Ecology; Amaresan, N., Senthil Kumar, M., Annapurna, K., Kumar, K., Sankaranarayanan, A., Eds.; Academic Press: Cambridge, MA, USA, 2020; pp. 571–591. [Google Scholar]
- Druzhinina, I.; Kubicek, C.P. Species Concepts and Biodiversity in Trichoderma and Hypocrea: From Aggregate Species to Species Clusters? J. Zhejiang Univ. Sci. B 2005, 6, 100–112. [Google Scholar] [CrossRef]
- Jaklitsch, W.M.; Voglmayr, H. Biodiversity of Trichoderma (Hypocreaceae) in Southern Europe and Macaronesia. Stud. Mycol. 2015, 80, 1–87. [Google Scholar] [CrossRef]
- Hermosa, M.R.; Keck, E.; Chamorro, I.; Rubio, B.; Sanz, L.; Vizcaíno, J.A.; Grondona, I.; Monte, E. Genetic Diversity Shown in Trichoderma Biocontrol Isolates. Mycol. Res. 2004, 108, 897–906. [Google Scholar] [CrossRef]
- de Oliveira da Silva, L.A.; Carmona, E.C. Production and Characterization of Cellulase-Free Xylanase from Trichoderma inhamatum. Appl. Biochem. Biotechnol. 2008, 150, 117–125. [Google Scholar] [CrossRef] [PubMed]
- Silva, L.A.O.; Terrasan, C.R.F.; Carmona, E.C. Purification and Characterization of Xylanases from Trichoderma inhamatum. Electron. J. Biotechnol. 2015, 18, 307–313. [Google Scholar] [CrossRef]
- Morales-Barrera, L.; Cristiani-Urbina, E. Hexavalent Chromium Removal by a Trichoderma inhamatum Fungal Strain Isolated from Tannery Effluent. Water Air Soil Pollut. 2008, 187, 327–336. [Google Scholar] [CrossRef]
- Kubicek, C.P.; Bissett, J.; Druzhinina, I.; Kullnig-Gradinger, C.; Szakacs, G. Genetic and Metabolic Diversity of Trichoderma: A Case Study on South-East Asian Isolates. Fungal Genet. Biol. 2003, 38, 310–319. [Google Scholar] [CrossRef]
- Bissett, J.; Gams, W.; Jaklitsch, W.; Samuels, G.J. Accepted Trichoderma names in the Year 2015. IMA Fungus 2015, 6, 263–295. [Google Scholar] [CrossRef] [PubMed]
- Nicoletti, R.; Vinale, F. Bioactive Compounds from Marine-derived Aspergillus, Penicillium, Talaromyces and Trichoderma Species. Mar. Drugs 2018, 16, 408. [Google Scholar] [CrossRef]
- Su, D.; Ding, L.; He, S. Marine-derived Trichoderma Species as a Promising Source of Bioactive Secondary Metabolites. Mini Rev. Med. Chem. 2018, 18, 1702–1713. [Google Scholar] [CrossRef]
- Song, Y.; Miao, F.; Liu, X.; Ji, N. Responses of Marine-derived Trichoderma Fungi to Seawater and Their Potential Antagonistic Behaviour. J. Ocean. Limnol. 2019, 37, 525–534. [Google Scholar] [CrossRef]
- Yao, M.L.C.; Villanueva, J.D.H.; Tumana, M.L.S.; Calimag, J.G.; Bungihan, M.E.; dela Cruz, T.E. Antimicrobial Activities of Marine Fungi Isolated from Seawater and Marine Sediments. Acta Manil. 2009, 57, 19–27. [Google Scholar]
- Torres, J.M.O.; Cardenas, C.V.; Moron, L.S.; Guzman, A.P.A.; dela Cruz, T.E.E. Dye Decolorization Activities of Marine-Derived Fungi Isolated from Manila Bay and Calatagan Bay, Philippines. Phil. J. Sci. 2011, 140, 133–143. [Google Scholar]
- Tan, W.S.; Ting, A.S.Y. Efficacy and Reusability of Alginate-Immobilized Live and Heat-Inactivated Trichoderma Asperellum Cells for Cu(II) Removal from Aqueous Solution. Bioresour. Technol. 2012, 123, 290–295. [Google Scholar] [CrossRef]
- Iskandar, N.L.; Zainudin, N.A.I.M.; Tan, S.G. Tolerance and Biosorption of Copper (Cu) and Lead (Pb) by Filamentous Fungi Isolated from a Freshwater Ecosystem. J. Environ. Sci. 2011, 23, 824–830. [Google Scholar] [CrossRef]
- Ban, Y.; Tang, M.; Chen, H.; Xu, Z.; Zhang, H.; Yang, Y. The Response of Dark Septate Endophytes (DSE) to Heavy Metals in Pure Culture. PLoS ONE 2012, 7, e47968. [Google Scholar] [CrossRef] [PubMed]
- Yan, G.; Viraraghavan, T. Heavy-Metal Removal from Aqueous Solution by Fungus Mucor rouxii. Water Res. 2003, 37, 4486–4496. [Google Scholar] [CrossRef]
- Hoseinzadeh, S.; Shahabivand, S.; Aliloo, A.A. Toxic Metals Accumulation in Trichoderma asperellum and T. harzianum. Microbiology 2017, 86, 728–736. [Google Scholar] [CrossRef]
- Sujatha, P.; Kalarani, V.; Naresh Kumar, B. Effective Biosorption of Nickel (II) from Aqueous Solutions Using Trichoderma viride. J. Chem. 2013, 716098. [Google Scholar] [CrossRef]
- Sarkar, S.; Satheshkumar, A.; Jayanthi, R.; Premkumar, R. Biosorption of Nickel by Live Biomass of Trichoderma harzianum. Res. J. Agric. Sci. 2010, 1, 69–74. [Google Scholar]
- Ab Rahman, N.N.N.; Shahadat, M.; Omar, F.M.; Chew, A.W.; Ab Kadir, M.O. Dry Trichoderma Biomass: Biosorption Behavior for the Treatment of Toxic Heavy Metal Ions. Desalin. Water Treat. 2016, 57, 13106–13112. [Google Scholar] [CrossRef]

| Habitats | Substrates | Taxa | Total Number of Isolates |
|---|---|---|---|
| Terrestrial | Soil | Trichoderma asperellum | 9 |
| Leaf Litter | Trichoderma asperellum Trichoderma harzianum Trichoderma virens | 3 2 1 | |
| Marine | Seagrass | Trichoderma virens | 1 |
| Seaweed | Trichoderma harzianum | 2 | |
| Sea foam | Trichoderma virens Trichoderma harzianum Trichoderma harzianum | 1 2 1 | |
| Marine water | Trichoderma inhamatum | 1 |
| Trichoderma Strains | Nickel Tolerance of Isolated Trichoderma at Different Concentrations (ppm) | ||||||
|---|---|---|---|---|---|---|---|
| 50 | 100 | 300 | 500 | 700 | 900 | 1200 | |
| T. harzianum LL01 | ++ | ++ | + | + | − | − | − |
| T. asperellum S02 | ++ | ++ | ++ | ++ | + | + | + |
| T. asperellum S03 | +++ | +++ | ++ | ++ | ++ | + | + |
| T. asperellum S04 | ++ | ++ | ++ | ++ | ++ | + | + |
| T. virens LL05 | +++ | +++ | ++ | ++ | ++ | + | + |
| T. asperellum LL06 | ++ | ++ | ++ | ++ | + | + | + |
| T. harzianum LL07 | ++ | ++ | + | + | + | − | − |
| T. asperellum S08 | ++ | ++ | ++ | ++ | + | + | + |
| T. asperellum S09 | ++ | ++ | ++ | ++ | ++ | + | + |
| T. asperellum S10 | ++ | ++ | ++ | ++ | + | + | + |
| T. asperellum S11 | ++ | ++ | ++ | ++ | + | + | + |
| T. asperellum S12 | ++ | ++ | ++ | ++ | + | + | + |
| T. asperellum S13 | ++ | ++ | ++ | ++ | ++ | + | + |
| T. asperellum LL14 | ++ | ++ | ++ | ++ | ++ | + | + |
| T. asperellum LL15 | ++ | ++ | ++ | ++ | + | + | + |
| T. harzianum AL16 | ++ | ++ | + | + | − | − | − |
| T. virens SW17 | ++ | ++ | ++ | ++ | − | + | − |
| T. virens SG18 | ++ | +++ | ++ | ++ | ++ | + | + |
| T. harzianum SF19 | ++ | ++ | ++ | + | ++ | + | + |
| T. harzianum SF21 | ++ | ++ | + | + | ++ | + | + |
| T. virens SF22 | ++ | ++ | ++ | + | ++ | + | + |
| T. harzianum SF23 | +++ | +++ | ++ | ++ | ++ | + | + |
| T. inhamatum MW25 | +++ | ++ | ++ | ++ | ++ | + | + |
| Trichoderma Strains a | Absorption of Nickel (NiSO4) by Trichoderma Biomass | |
|---|---|---|
| Conc. (ppm) | Percent Removal (%) | |
| T. asperellum (S03) | 16.86 | 66.28 |
| T. asperellum (S08) | 39.46 | 21.08 |
| T. asperellum (LL14) | 39.79 | 20.42 |
| T. virens (SG18) | 15.76 | 68.48 |
| T. virens (SF22) | 35.49 | 29.02 |
| T. inhamatum (MW25) | 15.86 | 68.28 |
Publisher’s Note: MDPI stays neutral with regard to jurisdictional claims in published maps and institutional affiliations. |
© 2021 by the authors. Licensee MDPI, Basel, Switzerland. This article is an open access article distributed under the terms and conditions of the Creative Commons Attribution (CC BY) license (https://creativecommons.org/licenses/by/4.0/).
Share and Cite
De Padua, J.C.; dela Cruz, T.E.E. Isolation and Characterization of Nickel-Tolerant Trichoderma Strains from Marine and Terrestrial Environments. J. Fungi 2021, 7, 591. https://doi.org/10.3390/jof7080591
De Padua JC, dela Cruz TEE. Isolation and Characterization of Nickel-Tolerant Trichoderma Strains from Marine and Terrestrial Environments. Journal of Fungi. 2021; 7(8):591. https://doi.org/10.3390/jof7080591
Chicago/Turabian StyleDe Padua, Jewel C., and Thomas Edison E. dela Cruz. 2021. "Isolation and Characterization of Nickel-Tolerant Trichoderma Strains from Marine and Terrestrial Environments" Journal of Fungi 7, no. 8: 591. https://doi.org/10.3390/jof7080591
APA StyleDe Padua, J. C., & dela Cruz, T. E. E. (2021). Isolation and Characterization of Nickel-Tolerant Trichoderma Strains from Marine and Terrestrial Environments. Journal of Fungi, 7(8), 591. https://doi.org/10.3390/jof7080591







